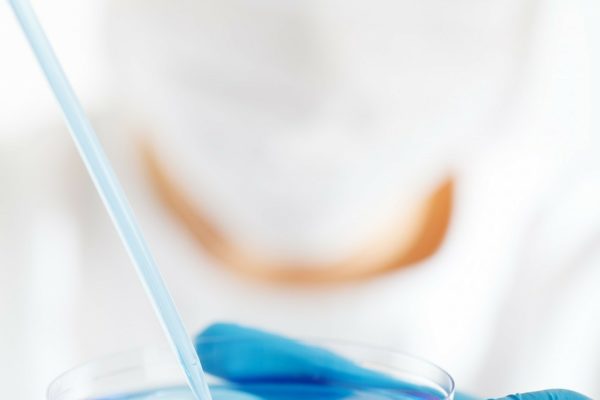

Esse site usa cookies, assim conseguimos prover a melhor experiência possível aos nossos usuários. Informações dos cookies são armazenadas no seu navegador e performam funções como reconhecer quando você retorna ao nosso site, nos ajudando a entender quais sessões do nosso site você acha mais interessante e útil.
Cookies Estritamente Necessários deve estar ativado o tempo todo, assim nós conseguimos salvar suas preferências para as configurações de cookies.
Se você desativar esse cookie, nós não poderemos salvar suas preferências. Isso significa que toda vez que você visitar nosso site, você terá que ativar ou desativar novamente os cookies.
Esse site usa Google Analytics para coletar informações anônimas, como número de visitantes, assim como as páginas mais visitadas.
Mantendo esse cookie ativado, você nos ajuda a melhorar o site.
<p>Por gentileza, ative os Cookies Estritamente Necessários primeiro, assim poderemos salvar suas preferências.</p>
Quando você acessa nosso site, nós, incluindo as empresas que contratamos para acompanhar como nosso site é usado, podemos colocar pequenos arquivos de dados chamados “cookies” no seu computador.
Enviamos um “cookie da sessão” para o seu computador quando você usa os Serviços da Regula Bem. Esse tipo de cookie nos ajuda a reconhecê-lo se visitar várias páginas em nosso site durante a mesma sessão, para que não precisemos solicitar a sua senha em todas as páginas. Depois que você sair ou fechar o seu navegador, esse cookie irá expirar e deixará de ter efeito.
Codificamos nossos cookies para que apenas nós possamos interpretar as informações armazenadas neles. Você está livre para recusar nossos cookies caso o seu navegador permita, mas isso pode interferir no uso do nosso site.
Nós e nossos prestadores de serviço também usamos cookies para personalizar nossos serviços, conteúdo e publicidade, avaliar a eficiência das promoções e promover confiança e segurança.
Você pode encontrar cookies de terceiros ao usar os Serviços da Copywrite em determinados sites que não estão sob nosso controle (por exemplo, se você visualizar uma página da Web criada por terceiros ou usar um aplicativo desenvolvido por terceiros, um cookie poderá ser colocado por essa página ou aplicativo).